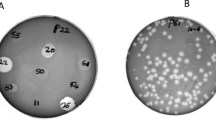

Abstract
Proteus mirabilis is one of the most frequent causes of catheter-associated urinary tract infections (CAUTIs) owing to its capability to colonize and develop crystalline multidrug-resistant (MDR) biofilms. Here, we report the isolation and partial characterization of three novel bacteriophages, vB_PmiM-ES1a, vB_PmiM-ES1b, and vB_PmiM-ES1c, which were active against the planktonic form and biofilms of the MDR P. mirabilis strain ES01, isolated from CAUTIs in Egypt. The antibiotic susceptibility profile of the P. mirabilis isolates showed resistance to most of the antibiotics tested. The isolated phages were identified morphologically using TEM, and each appeared to have myovirus-like morphology. The three phages displayed strong lytic activity and a narrow host range, and they were stable at different ranges of temperatures and pH values. One-step growth kinetics showed a lysis time of 180 min with a burst size of 99.6, 95, and 86 PFU/cell for phage vB_PmiM-ES1a, vB_PmiM-ES1b, and vB_PmiM-ES1c, respectively. The three phages exhibited different digestion patterns using different restriction enzymes. The genome size was estimated to be 59.39 kb, 62.19 kb, and 52.07 kb for phage vB_PmiM-ES1a, vB_PmiM-ES1b, and vB_PmiM-ES1c, respectively. A phage cocktail including the three phages showed a potential ability to reduce and eradicate a biofilm formed by the MDR Proteus mirabilis EG-ES1. Accordingly, a phage cocktail of vB_PmiM-ES1a, vB_PmiM-ES1b, and vB_PmiM-ES1c is considered a promising candidate for use as a biocontrol agent against MDR Proteus mirabilis bacteria.
Similar content being viewed by others
Avoid common mistakes on your manuscript.
Introduction
Proteus mirabilis is a Gram-negative bacterium of the order Enterobacterales that is a commensal component of the human gastrointestinal microflora [1]. It is also an opportunistic and common etiologic pathogen of catheter-associated urinary tract infections (CAUTIs), meningitis in neonates and infants, wound infections [2], diabetic foot infections [3], and rheumatoid arthritis [4, 5]. P. mirabilis infection frequently leads to accumulation and blockage of catheters in CAUTI patients through the formation of crystalline biofilms, which, if not noticed, can block the urine flow and result in reflux of the urine to the upper urinary tract, resulting in severe clinical manifestations including acute pyelonephritis and septicemia [6,7,8]. Catheter blockage is due to the ability of P. mirabilis to form dense crystalline biofilms [4, 9] and to produce the enzyme urease [10, 11], which hydrolyses urea in the urine and produces ammonia, which in turn increases the urinary pH [12,13,14]. This alkaline environment stimulates magnesium and calcium phosphates to accumulate and generate microcrystalline aggregates [7, 14]. As these crystals continue to grow, they ultimately form a mineralized crystalline biofilm structure that blocks the urine [7, 14, 15]. Although some catheters have been designed to inhibit biofilm formation and prevent CAUTIs, they remain susceptible to encrustation and blockage by P. mirabilis and are therefore considered ineffective for long-term use [8, 14, 16]. Moreover, P. mirabilis can cause chronic infections in long-term catheterized patients that remain even after catheter changes and multiple rounds of antibiotic treatment [14, 17].
Bacteria that inhabit urinary catheters are frequently resistant to various antibiotics, and consequently, biofilms generated by those indwelling bacteria are reservoirs of antibiotic-resistant bacteria [18, 19]. Although antibiotic treatment is successful in most cases, the overuse and misuse of antibiotics has led to a marked increase in multidrug resistance (MDR) in CAUTI-causing bacteria [19, 20]. The first MDR P. mirabilis was reported in 1978 [21], and recently, the number of clinically isolated MDR P. mirabilis strains has increased dramatically [22,23,24]. This indicates that the current strategies to treat CAUTIs are not entirely effective, highlighting the need for new preventive alternatives to solve this persistent and increasing problem. One of the novel strategies that are currently under investigation is the application of bacteriophages. Lytic phages disrupt bacterial metabolism and exponentially replicate in their hosts, irrespective of any multidrug resistance [25,26,27].
Bacteriophages infecting Proteus sp. were isolated and described for the first time in 1958 [28]. Later, Proteus phages were reported in several studies, and they were used to type P. mirabilis [29] and were tested as antibacterial agents [30]. The application of bacteriophages to combat MDR P. mirabilis and to eradicate their biofilms has been extensively investigated [14, 19, 24, 31,32,33,34]. In this paper, we report the discovery of three lytic P. mirabilis-specific bacteriophages infecting an MDR P. mirabilis isolate, and the ability of these phages to combat and eliminate biofilms of P. mirabilis was investigated.
Materials and methods
Bacterial strains and culture conditions
The current study was performed on five clinical isolates of P. mirabilis that had been obtained from patients at Benha University Hospital (Benha, Qualubia province, Egypt) with urinary tract infections. The complete list of different bacterial strains is provided in Supplementary Table S1. All isolates were stored in sterilized brain heart infusion medium supplemented with 20% (v/v) glycerol and were kept at − 80°C. Fresh overnight cultures were prepared by transferring a single pure colony into 5 ml of nutrient broth medium and incubation for 16 h at 37 °C with rocking at 200 rpm. The isolates of Proteus mirabilis were identified morphologically and biochemically (Supplementary Table S2). A VITEK® 2 COMPACT automated instrument was used to confirm the isolates.
Antibiotic susceptibility testing
Antibiotic susceptibility testing was performed on Mueller-Hinton agar medium using the Kirby-Bauer disc diffusion method [35] for the following antibiotics (Oxoid, Hampshire, UK): aztreonam (30 µg), amoxicillin (25 µg), norfloxacin (30 µg), tobramycin (10 µg), ciprofloxacin (5 µg), cefoxitin (30 µg), streptomycin (10 µg), cefaclor (30 µg), ceftriaxone (30 µg), imipenem (10 µg), ceftazidime (30 µg), cephalexin (30 µg), ofloxacin (5 µg), azithromycin (15 µg), trimethoprim-sulfamethoxazole (25 µg), and cefotaxime (30 µg). The results were interpreted using the standards of the Clinical and Laboratory Standards Institute (CLSI) [36].
Quantitative evaluation of biofilm formation by Proteus mirabilis
The potential of P. mirabilis isolates to produce biofilms was estimated according to Stepanovic et al. [37] with some modification. In each well of a 96-well microtiter plate, fresh P. mirabilis cultures (final concentration, 4 log10 CFU/ml) were inoculated into tryptone soya broth (TSB), and the plate was then incubated for 24 h under static conditions at 37 °C. Negative control samples containing bacteria-free TSB were included. Subsequently, the plates were decanted, washed three times with phosphate-buffered saline (PBS), and allowed to air-dry. The remaining attached bacteria were fixed for 10 minutes in 150 µl of 98% methanol, the methanol was removed, and the plates were air-dried. The plates were then stained with 1% crystal violet for 45 min and eluted using 33% acetic acid. A microplate reader (BMG LABTECH GmbH, Allmendgrun, Germany [38] was used to measure the optical density at 570 nm.
An optical density cutoff (ODc) was used to judge and classify biofilm-generating strains according to Stepanovic et al. [37] into non-biofilm producers (OD ≤ ODc), weak biofilm producers (2 × ODc ≥ OD > ODc), moderate biofilm producers (4 × ODc ≥ OD > 2× ODc) and strong biofilm producers (OD > 4 × ODc), where ODc = average OD of negative control + (3 × SD of negative control).
Mitomycin C induction to identify prophage-free Proteus mirabilis
The MDR and strong biofilm producer P. mirabilis strain EG-ES1 was used for the isolation, purification, and propagation of bacteriophages. Before the isolation of lytic phages, P. mirabilis EG-ES1 was tested for lysogens using a mitomycin C induction protocol [39]. In Brief, 5 ml of fresh P. mirabilis EG-ES1 culture was treated with 200 µg of mitomycin C (Sigma-Aldrich, St. Louis, MO, USA) per ml and incubated under normal growth condition. Proteus growth was monitored by measuring the OD at 600 nm. At various time points, 500-µl aliquots of the culture were collected and centrifuged to remove residual bacteria. They were then tested for lysogenic phage induction by spotting 10 µl of the supernatant onto a lawn of a marker host and incubating at 37°C for 24 h [25, 39].
Bacteriophage enrichment and isolation
Bacteriophages were isolated from raw sewage water samples from different districts in Qalubiya governorate, Egypt, as described previously [40]. The collected sewage samples were processed to remove solids and cellular microorganisms, and lytic phages were isolated by the enrichment method [34]. Briefly, 5 ml of sterile 2× TSB and 150 µl of fresh P. mirabilis EG-ES1 culture were mixed with 5 ml of a 0.22-µm-filtered sewage sample and incubated at 37°C for 24 h with shaking at 200 rpm. The enriched samples were then centrifuged at 5000 × g for 10 min, and the supernatants were filtered using 0.22-µm membrane filters (mixed cellulose ester, MF-Millipore, Burlington, MA, USA). To screen for phages, 10 µl of each supernatant was spotted onto a lawn of an indicator Proteus strain and incubated at 37°C for 24 h [25, 41]. The plates were inspected for the development of lysis zones, and any lysis zone was removed from the TSA plate using a sterile pipette tip, transferred to a fresh tube containing 200 µl of salt-magnesium (SM) buffer (0.05 M Tris-HCl, 0.1 M NaCl, and 0.01 M MgSO4, pH 7.5), and incubated overnight at room temperature to permit the phages to disperse into the SM buffer.
Phages were purified by three rounds of single-plaque isolation, employing the double-layer agar (DLA) method [42]. Briefly, plaques with different dimensions and morphologies were picked from the double agar overlay plates using sterilized toothpicks, individually resuspended in 200 µl of SM buffer, and kept overnight at room temperature. Then, the resuspended plaques were plated again using the DLA technique, and the isolation of single plaques was repeated three times sequentially.
Preparation and purification of high-titre phage stocks
The isolated bacteriophages were propagated as described previously [43]. One hundred milliliters of a mid-log culture of the indicator P. mirabilis EG-ES1 (OD600 = 0.6) was infected with a purified phage suspension at a multiplicity of infection (MOI) of 1. The infected culture was incubated at 37°C for 24 h with shaking at 200 rpm, phage particles were precipitated from the bacterial debris using polyethylene glycol (PEG), and the phage-PEG complex was dispersed in SM buffer. Finally, phages were released from the PEG using chloroform extraction [24, 43]. Propagated phages were subsequently filter-sterilized using 0.22-µm membrane filters and kept at 4 °C until further analysis. The phage titer (PFU/ml) was determined using the DLA method.
Transmission electron microscopy (TEM)
Ten microliters of pure phage suspension was placed onto a 300-mesh copper TEM grid (Electron Microscopy Sciences) supported by carbon-coated Formvar film [44]. The phage particles were fixed for 5 min and then were negatively stained with 2% (w/v) phosphotungstic acid, pH 7.2, for 1 min and air-dried at room temperature for 1 h. Phage particles were imaged using a transmission microscope (A JEOL JEM-2100) at the Microscope Facility, Al-Azhar University, Egypt.
One-step growth curve
The growth kinetics and burst sizes of the three isolated phages were determined as described previously [19, 25] with some modifications. Briefly, a fixed number of P. mirabilis EG-ES1 cells in mid-log-phase were inoculated with each phage at an MOI of 1. After 5 min of adsorption at 37°C with shaking at 120 rpm, the mixture was centrifuged at 7000 × g for 5 min. The phage-bacterial pellets were washed twice to remove free unbound phage and redissolved in 10 ml of fresh TSB. Aliquots of infected cell supernatant were collected for 3 hours postinfection (p.i.). To determine the latent period and plot the growth kinetics, phage titers were calculated using a plaque assay [42]. The mean burst size (plaque-forming units per cell) was calculated and plotted against time postinfection.
Determination of phage host range
The host range for the three isolated phages individually as well as for a cocktail of the three phages at a ratio of 1:1:1 was investigated using nine Proteus strains and a cohort of 13 non-proteus strains (Table S1, Supplementary data) as described previously with some modifications [39, 45]. About 10 µl of each phage suspension at a concentration of 108 PFU/ml was spotted, in duplicate, onto a lawn of the tested bacteria. The plates were incubated at 37 °C for 24 h before being tested for clear zones.
Thermal and pH stability
The thermal and pH stability of the selected phages was evaluated as described previously [25]. For thermal stability, 100 µl of each phage suspension (1010 PFU/ml) was added to 900 µl of pre-warmed sterilized 2× TSB medium and incubated in a water bath at 10 °C, 25 °C, 37 °C, 50 °C, 60 °C, or 70 °C for 60 min at pH 7.0. For pH stability evaluation, pure phage lysates (1010 PFU/ml) were diluted in 2× TSB at different pH values ranging from 2 to 12 (adjusted with NaOH and HCl) and then incubated for 24 h at 37 °C. The treated phage suspensions were then serially diluted, and the remaining infectivity was evaluated by counting plaques on lawns of P. mirabilis EG-ES1 using the double-layer agar method [39]. Temperature and pH experiments were repeated three times, and the average was calculated. After each treatment, the percentage of residual phage activity was calculated using the following equation:
Purification of phage DNA and restriction profile analysis
Phage genomic DNA was extracted using a Wizard® Genomic DNA Purification Kit (Promega Company, Madison, USA) according to the manufacturer's protocol. For BamHI digestion, 10 µl of phage genomic DNA (1 µg) was mixed with 1 µl of the enzyme (20 U), 2 µl of restriction buffer (10× buffer), and water up to 20 µl, and the mixture was incubated at 30 °C for 5 min. Similarly, 1 µg of phage DNA was digested at 37 °C in a solution containing PstI enzyme, the corresponding buffer, and water. Restriction enzymes and their accompanying buffers were provided by Takara Biomedical. After digestion, the sizes of the restriction fragments were estimated by electrophoresis using an Agilent 2100 Bioanalyzer (Agilent Technologies, cat. no. G2939BA). The results were analyzed and visualized using 2100 Expert software (Agilent Technologies, USA).
Susceptibility of planktonic cells of P. mirabilis to the isolated phages
The bactericidal effect of the three isolated phages on free cells of P. mirabilis EG-ES1 was determined by measuring the optical density (OD600) for 24 h postinfection as described previously [25]. Briefly, 100 µl of P. mirabilis EG-ES1 cells (7 log10 CFU/mL) in mid-log-phase were inoculated in a 96-well microplate with each phage at an MOI of 0.1, 1, 5, 10, or 100. The negative control contained a mixture of equal volumes of P. mirabilis EG-ES1 and TSB. The plates were incubated statically at 37°C for 24 h, and the optical density was then measured at 600 nm using a microplate reader (BMG LABTECH GmbH, Allmendgrun, Germany) [38].
Anti‑biofilm activity of a cocktail of the isolated phages
The three isolated phages were mixed in a ratio of 1:1:1, with each phage present at a titer of 9 log10 PFU/ml. The ability of the phage cocktail to disrupt biofilms generated by P. mirabilis EG-ES1 was tested using a quantitative colorimetric method described previously [25, 46, 47] with some modification. In each well of a 96-well flat-bottom polystyrene microtiter plate, 10 µl of P. mirabilis EG-ES1 (final concentration, 5 log10 CFU/ml) was inoculated into 180 µl of tryptone soy broth (TSB) medium and then incubated statically at 37°C for 24 h to allow biofilm formation. The bacteria in the wells were then treated in duplicate with the phage cocktail mix at a final titer of 8 log10 PFU/ml or 9 log10 PFU/ml, and equivalent volumes of PBS were used for negative control wells. The plates were incubated statically at 37°C for 24 h, the free contents of each plate were decanted, and the wells were washed three times with 200 µl of PBS. The plates were allowed to air-dry and were then fixed and stained as described above. Optical density was measured at 570 nm using a microplate reader (BMG LABTECH GmbH, Allmendgrun, Germany) [38].
The percentage of biofilms inhibition was determined as follows:
Results
Proteus bacteria and antibiotic susceptibility testing
Five isolates of Proteus mirabilis were isolated previously at Benha University Hospital. Those isolates were selected for this study based on their antibiotic resistance level. The bacteria were identified morphologically and biochemically by conventional methods (Supplementary Table S2), and their biochemical profiles were consistent with those of Proteus mirabilis. Further confirmation of the isolates was done using a VITEK® 2 system. These isolates were designated as Proteus mirabilis EG-ES1, EG-ES2, EG-ES3, EG-ES4, and EG-ES5.
The antibiotic susceptibility of the five Proteus isolates was evaluated against a selection of 16 antibiotics of different categories (Table 1). An antibiogram profile showed that the five P. mirabilis isolates were resistant to at least 56.25% of the tested antibiotics of more than three different antimicrobial classes and were consequently recognized as multidrug resistant (MDR). P. mirabilis EG-ES1 was the most MDR isolate, with resistance to 87.5% of the tested antibiotics. All of the isolates were susceptible to imipenem and cefoxitin.
Quantitative evaluation of biofilm formation by Proteus mirabilis
The ability to generate biofilms was assessed for all five Proteus mirabilis isolates. The optical density cutoff value (ODc) was calculated to be 0.05 (negative control; uninoculated tryptone soy broth). Based on their biofilm generation capability (Fig. 1), the Proteus mirabilis isolates were divided into three categories. One isolate, P. mirabilis EG-ES5, was found to be a non-biofilm producer (OD < 0.05), P. mirabilis EG-ES2, EG-ES3, and EG-ES4 were identified as moderate biofilm producers (0.2 ≥ OD > 0.05), and P. mirabilis EG-ES1 was shown to be a strong biofilm producer (OD > 0.2).
Isolation, selection, and lytic activity of bacteriophages
The preceding experiments demonstrated that P. mirabilis EG-ES1 is an extreme MDR and strong biofilm producer. Consequently it was selected as a marker host to isolate lytic bacteriophages. First, P. mirabilis EG-ES1 was tested for the presence of any temperate (lysogenic) phages, using mitomycin C. The experiment did not show any induction of temperate phages, suggesting that P. mirabilis EG-ES1 was prophage-free and therefore suitable as a host for phage isolation.
Three lytic phages were successfully isolated, purified, and propagated in P. mirabilis. The phages vB_PmiM-ES1a, vB_PmiM-ES1b, and vB_PmiM-ES1c were obtained after screening 50 sewage water samples from Qalubiya governorate, Egypt. The three isolates initially differed in the size, shape, and turbidity of the plaques they produced (Supplementary Fig. S2). Sequential plaque isolation resulted in isolation of single pure phages, all of which produced small circular plaques with a diameter of 1-2 mm.
Characterization of the isolated phages
Morphology, growth kinetics, and host range
TEM micrographs (Fig. 2A-C) showed that the three isolated phages have icosahedral heads with contractile tails, suggesting that they have a myovirus-like morphotype. The corresponding dimensions of the heads and tails of the isolated phages were calculated.
TEM morphology and one-step growth curves of the isolated Proteus mirabilis phages. (A-C) TEM micrographs of phages. vB_PmiM-ES1a, vB_PmiM-ES1b, and vB_PmiM-ES1c were negatively stained with 0.2% uranyl acetate as described in “Materials and methods”. Scale bar = 100 nm. (D-F) growth kinetics of vB_PmiM-ES1a, vB_PmiM-ES1b, and vB_PmiM-ES1c, respectively, on Proteus mirabilis EG-ES1
The one-step growth kinetics of the three isolated Proteus phages (Fig. 2D-F) were examined to investigate their infection cycle and to determine their latent period and burst sizes. The three phages were found to have the same latent period (15 min), and they needed 3 h to complete their infection cycle. Under normal infection and incubation conditions, phages vB_PmiM-ES1a, vB_PmiM-ES1b, and vB_PmiM-ES1c had a burst size of 99.6, 95, and 86 PFU/cell, respectively.
The host range of each of the isolated phages and of a cocktail of these phages was determined (Table 2). The phage cocktail exhibited a broader spectrum than the individual phages. The phage cocktail lysed three of the nine Proteus strains tested. Among the tested single phages, vB_PmiM-ES1b showed the most lytic activity against these host strains. None of the phages were observed to lyse members of other bacterial genera.
Thermal and pH stability
The thermal and pH stability of phages vB_PmiM-ES1a, vB_PmiM-ES1b, and vB_PmiM-ES1c was evaluated by measuring the percentage of lytic activity remaining after incubation at different temperatures and pH values (Fig. 3). The isolated phages were found to be stable from 10 °C to 37 °C. The phage titers decreased by 50% and 80% after heating at 50 °C and 60 °C, respectively. The three phages completely lost their viability, and no viable plaques were observed after heating at 70 °C for 60 min (Fig. 3A-C). Concerning pH stability, the three isolated phages resisted inactivation for 24 h in the pH range of 4-10, with the preferred pH values in the range of 6-8 (Fig. 3D-F).
Thermal and pH stability of Proteus mirabilis phages. (A-C) pH stability of vB_PmiM-ES1a, vB_PmiM-ES1b, and vB_PmiM-ES1c, respectively. (D-F) Thermal tolerance of vB_PmiM-ES1a, vB_PmiM-ES1b, and vB_PmiM-ES1c, respectively. pH experiments were performed for 24 h at 37°C. Temperature testing was performed for 60 min at pH 7. Data represent the percentage of lytic activity remaining after each treatment relative to the control. Data are reported as the mean of three independent experiments, and error bars show the standard deviation.
Restriction digestion patterns
The three isolated Proteus phages displayed different restriction digestion profiles following BamHI and PstI digestion (Supplementary Fig. S3). This confirmed that the three phages were genetically different. The genome sizes of the isolated phages were calculated by adding the sizes of the fragments formed by digestion with the restriction enzyme (Supplementary Table S3). The genome size was approximately 59.39 kb, 62.19 kb, and 52.07 kb for phage vB_PmiM-ES1a, vB_PmiM-ES1b, and vB_PmiM-ES1c, respectively.
Susceptibility of planktonic cells of P. mirabilis to the isolated phages
Planktonic cultures of P. mirabilis EG-ES1 were tested for their susceptibility to each of the phages at different MOIs within 24 h (Fig. 4). The data showed that each of the phages successfully obstructed host growth by 2 h postinfection (p.i.) as compared with the uninfected control. A greater disruption of planktonic cell growth was observed at a higher MOI than at a lower MOI. A slight increase in the growth of phage-challenged bacteria was observed after 6 h p.i., but the counts were significantly lower than those of the uninfected control. The results show that the three phages have sustained strong lytic activity after continued incubation at different MOIs.
Anti‑biofilm activity of a cocktail of bacteriophages
The biofilm disruption activity of a phage cocktail composed of a 1:1:1 mixture of the three isolated phages against biofilms of P. mirabilis EG-ES1 was evaluated in a 96-well microtiter plate at 37°C using titers of 8 log10 PFU/mL and 9 log10 PFU/mL (Fig. 5). There was a considerable reduction in the number of viable bacterial cells embedded in the biofilm solution after challenge with the phage cocktail. Biofilm inhibition of 44.40% and 56.26% was observed at a final phage titer of 8 log10 PFU/ml and 9 log10 PFU/ml, respectively.
Discussion
Proteus mirabilis is a member of the normal human intestinal microflora, but it is opportunistic and can cause different human infections [48, 49], which are associated with biofilm formation. Biofilms produced by P. mirabilis are often crusted and offer a good niche for bacterial cells, shielding them from different factors, such as antibiotics [8, 50]. Antibiotic resistance occurs naturally, but excessive and uncontrolled use of antibiotics has resulted in the quick spread of resistance [51]. Antibiotic-resistant bacteria are emerging very quickly, mostly in developing countries [52,53,54]. Egypt is one of the countries that have lax restrictions on antibiotic use [55,56,57], mainly because antibiotics can be obtained directly from pharmacies and drug stores with no prescription [54, 58].
Antibiotic resistance restricts the successful therapy of bacterial infections, and this is a critical threat to global public health. Resistance of P. mirabilis to commonly used antimicrobials is related to the biofilm lifestyle. Five P. mirabilis isolates that were isolated previously from Benha University Hospital were targeted in this study. The P. mirabilis isolates were identified biochemically and by employing an automated Vitek 2 system. P. mirabilis isolates were found to be MDR with varying degrees of biofilm formation capability. The isolate EG-ES1 was the most MDR and the strongest biofilm producer of the five. Multidrug-resistant Proteus spp. have been isolated previously in Egypt [59, 60]. Lately, the spread of MDR pathogenic bacteria has forced researchers to find new alternative therapies. Of these alternative therapies, bacteriophages have been considered good candidates to control biofilm infections [61].
Previously, five lytic phages infecting MDR P. mirabilis isolates were isolated from sewage in Egypt [34]. In the current study, three different lytic phages were isolated from raw sewage water targeting the MDR Proteus mirabilis EG-ES1. On P. mirabilis EG-ES1 lawns, the three phages showed differences in the plaque size, shape, and turbidity. They produced small circular and clear plaques with no halos. Phages with different morphologies and sizes targeting P. mirabilis were isolated and described previously [24, 34, 62, 63].
For additional characterization, TEM imaging and one-step growth kinetics were performed for the three phages. The growth curves of the three phages exhibited typical growth kinetics of bacteriophages. TEM micrographs showed that the three phages have icosahedral capsids with contractile tails and hence have characteristics of members of the family Myoviridae in the order Caudovirales. P. mirabilis phages belonging to the family Myoviridae have been isolated previously [19, 64], but many other phages belonging to the families Podoviridae and Siphoviridae have also been described [32]. DNA sequencing studies are required to determine to which families the isolated phages belong.
Host range experiments showed that the three individual phages have narrow host ranges with lytic activity against only three P. mirabilis isolates in the current study. Bacteriophages are highly specific for their host cell receptors [65], and this high specificity is considered a major limitation of phage therapy. However, this problem might be overcome by using phage cocktails to broaden the host range [66, 67]. Our data showed that a cocktail of the three isolated P. mirabilis phages had a broader host spectrum than the individual phages alone. This may be due to different phages in the cocktail recognizing different receptor sites on the bacterial cell wall.
Stability under different stress conditions is an important consideration for the application of phage for therapy. A previous study showed that a lytic Proteus mirabilis phage was thermostable and resisted heating up to 75°C for 1 h [63]. Our results showed that the three isolated phages were partially stable at temperatures up to 60 °C for 1 h but completely lost their lytic activity when heated at ≥70 °C for 1 h. P. mirabilis produces a urease enzyme that plays an important role in the generation of the crystalline biofilm [10, 11] and increases the pH of the urine to 8-9. On the other hand, the accumulation of acidic substances can reduce the pH of the matrix of the biofilm [33]. Application of bacteriophages in an environment where the pH fluctuates will only succeed if the phages tolerate a wide range of pH values. Our results indicated that the three isolates remained stable over a wide pH range (pH 3-10) but completely lost their lytic activities at pH < 4 or > 10.
The disruptive effect of the three isolated phages on planktonic cultures of P. mirabilis EG-ES1 demonstrated the lytic activity of the three phages at higher and lower MOIs. Biofilms of P. mirabilis create a therapeutic dilemma due to their acute resistance to different antimicrobial agents. In the current study, we have tested a cocktail of three phages to eliminate biofilms of P. mirabilis EG-ES1. The results showed the reduction of pre-formed biofilms by 44.40% and 56.26% using phage cocktails at final titers of 8 log10 PFU/ml and 9 log10 PFU/ml, respectively. The eradication activity of the phages in this study was higher than that reported by Carson et al. [33], who detected only 10% inhibition of a P. mirabilis biofilm. In contrast, two other studies [34, 63] showed inhibition activity of more than 60% on biofilms of P. mirabilis challenged with different bacteriophages against P. mirabilis.
The results in this study revealed the potential of three isolated bacteriophages to combat the biofilms of a multidrug-resistant P. mirabilis strain in vitro. Although phage therapy as an alternative therapeutic approach has many advantages over antibiotics, there is a lack of appropriately verified clinical research on phage therapy, and there are no well-established protocols for the dose, route of administration, and length of therapy.
Conclusion
Proteus mirabilis is an opportunistic pathogenic Gram-negative bacillus that causes catheter-associated urinary tract infections (CAUTIs). Multidrug-resistant isolates with biofilm formation ability were found in this study. The generation of crystalline biofilm is considered a virulence factor that also contributes to the high rate of antibiotic resistance. In the current study, we isolated and characterized three novel bacteriophages from Egypt infecting MDR P. mirabilis. Bacteriophages have been used extensively as a promising alternative to treat biofilm-associated MDR P. mirabilis. Our results showed the efficacy of a phage cocktail to control and eradicate biofilm-associated infections of MDR P. mirabilis.
References
Girlich D, Bonnin RA, Dortet L, Naas T (2020) Genetics of acquired antibiotic resistance genes in Proteus spp. Front Microbiol 11:1–21
Rózalski A, Sidorczyk Z, Kotełko K (1997) Potential virulence factors of Proteus bacilli. Microbiol Mol Biol Rev 61:65–89. https://doi.org/10.1128/.61.1.65-89.1997
Shanmugam P, Jeya M, Linda SS (2013) The bacteriology of diabetic foot ulcers, with a special reference to multidrug resistant strains. J Clin Diagnostic Res 7:441–445. https://doi.org/10.7860/JCDR/2013/5091.2794
Schaffer JN, Pearson MM (2016) Proteus mirabilis and urinary tract infections. In: Urinary tract infections: molecular pathogenesis and clinical management. Taylor & Francis, pp 383–433
O’Hara CM, Brenner FW, Miller JM (2000) Classification, identification, and clinical significance of Proteus, Providencia, and Morganella. Clin Microbiol Rev 13:534–546
Mobley HLT, Belas R, Lockatell V et al (1996) Construction of a flagellum-negative mutant of Proteus mirabilis: effect on internalization by human renal epithelial cells and virulence in a mouse model of ascending urinary tract infection. Infect Immun 64:5332–5340. https://doi.org/10.1128/iai.64.12.5332-5340.1996
Stickler DJ (2008) Bacterial biofilms in patients with indwelling urinary catheters. Nat Clin Pract Urol 5:598–608
Stickler DJ (2014) Clinical complications of urinary catheters caused by crystalline biofilms: something needs to be done. J Intern Med 276:120–129
Armbruster CE, Mobley HLT (2012) Merging mythology and morphology: the multifaceted lifestyle of Proteus mirabilis. Nat Rev Microbiol 10:743–754
Broomfield RJ, Morgan SD, Khan A, Stickler DJ (2009) Crystalline bacterial biofilm formation on urinary catheters by urease-producing urinary tract pathogens: a simple method of control. J Med Microbiol 58:1367–1375. https://doi.org/10.1099/jmm.0.012419-0
Stickler D, Morris N, Moreno MC, Sabbuba N (1998) Studies on the formation of crystalline bacterial biofilms on urethral catheters. Eur J Clin Microbiol Infect Dis 17:649–652. https://doi.org/10.1007/s100960050150
Holling N, Dedi C, Jones CE et al (2014) Evaluation of environmental scanning electron microscopy for analysis of Proteus mirabilis crystalline biofilms in situ on urinary catheters. FEMS Microbiol Lett 355:20–27. https://doi.org/10.1111/1574-6968.12451
Holling N, Lednor D, Tsang S et al (2014) Elucidating the genetic basis of crystalline biofilm formation in Proteus mirabilis. Infect Immun 82:1616–1626. https://doi.org/10.1128/IAI.01652-13
Alves DR, Nzakizwanayo J, Dedi C et al (2019) Genomic and ecogenomic characterization of Proteus mirabilis bacteriophages. Front Microbiol 10:1–14. https://doi.org/10.3389/fmicb.2019.01783
Stickler D, Ganderton L, King J et al (1993) Proteus mirabilis biofilms and the encrustation of urethral catheters. Urol Res 21:407–411. https://doi.org/10.1007/BF00300077
Morgan SD, Rigby D, Stickler DJ (2009) A study of the structure of the crystalline bacterial biofilms that can encrust and block silver Foley catheters. Urol Res 37:89–93. https://doi.org/10.1007/s00240-009-0176-6
Kunin CM (1997) Urinary tract infections. Detection, prevention, and management. Williams & Wilkins, Philadelphia
Chenoweth CE, Gould CV, Saint S (2014) Diagnosis, management, and prevention of catheter-associated urinary tract infections. Infect Dis Clin 28:105–119
Melo LDR, Veiga P, Cerca N et al (2016) Development of a phage cocktail to control Proteus mirabilis catheter-associated urinary tract infections. Front Microbiol. https://doi.org/10.3389/fmicb.2016.01024
Wang JT, Chen PC, Chang SC et al (2014) Antimicrobial susceptibilities of Proteus mirabilis: a longitudinal nationwide study from the Taiwan surveillance of antimicrobial resistance (TSAR) program. BMC Infect Dis 14:1–10. https://doi.org/10.1186/1471-2334-14-486
Yoshikawa TT, Shibata SA, Chow AW, Guze LB (1978) Outbreak of multiply drug-resistant Proteus mirabilis originating in a surgical intensive care unit: in vitro susceptibility pattern. Antimicrob Agents Chemother 13:177–179. https://doi.org/10.1128/AAC.13.2.177
Chong Y, Shimoda S, Yakushiji H et al (2013) Community spread of extended-spectrum β-lactamase-producing Escherichia coli, Klebsiella pneumoniae and Proteus mirabilis: a long-term study in Japan. J Med Microbiol 62:1038–1043. https://doi.org/10.1099/jmm.0.059279-0
Cohen-Nahum K, Saidel-Odes L, Riesenberg K et al (2010) Urinary tract infections caused by multi-drug resistant proteus mirabilis: risk factors and clinical outcomes. Infection 38:41–46. https://doi.org/10.1007/s15010-009-8460-5
Morozova V, Kozlova Y, Shedko E et al (2018) Isolation and characterization of a group of new Proteus bacteriophages. Arch Virol 163:2189–2197. https://doi.org/10.1007/s00705-018-3853-3
Esmael A, Azab E, Gobouri AA et al (2021) Isolation and characterization of two lytic bacteriophages infecting a multi-drug resistant salmonella typhimurium and their efficacy to combat salmonellosis in ready-to-use foods. Microorganisms 9:1–19. https://doi.org/10.3390/microorganisms9020423
Moye ZD, Woolston J, Sulakvelidze A (2018) Bacteriophage applications for food production and processing. Viruses 10(4):205. https://doi.org/10.3390/v10040205
Doss J, Culbertson K, Hahn D et al (2017) A review of phage therapy against bacterial pathogens of aquatic and terrestrial organisms. Viruses 9(3):50. https://doi.org/10.3390/v9030050
Taubeneck U (1963) Demonstration of lysogeny in stable l forms of Proteus mirabilis. J Bacteriol 86:1265–1269. https://doi.org/10.1128/jb.86.6.1265-1269.1963
France DR, Markham NP (1968) Epidemiological aspects of Proteus infections with particular reference to phage typing. J Clin Pathol 21:97–102. https://doi.org/10.1136/jcp.21.1.97
Witoszka M, Strumillo B (1963) Attempted treatment of infected wounds with bacteriophage. Pol Przegl Chir 35:1054–1106
Lehman SM, Donlan RM (2015) Bacteriophage-mediated control of a two-species biofilm formed by microorganisms causing catheter-associated urinary tract infections in an in vitro urinary catheter model. Antimicrob Agents Chemother 59:1127–1137. https://doi.org/10.1128/AAC.03786-14
Nzakizwanayo J, Hanin A, Alves DR et al (2016) Bacteriophage can prevent encrustation and blockage of urinary catheters by Proteus mirabilis. Antimicrob Agents Chemother 60:1530–1536. https://doi.org/10.1128/AAC.02685-15
Carson L, Gorman SP, Gilmore BF (2010) The use of lytic bacteriophages in the prevention and eradication of biofilms of Proteus mirabilis and Escherichia coli. FEMS Immunol Med Microbiol 59:447–455. https://doi.org/10.1111/j.1574-695X.2010.00696.x
Gomaa S, Serry F, Abdellatif H, Abbas H (2019) Elimination of multidrug-resistant Proteus mirabilis biofilms using bacteriophages. Arch Virol 164:2265–2275. https://doi.org/10.1007/s00705-019-04305-x
Biemer JJ (1973) Antimicrobial susceptibility testing by the Kirby-Bauer disc diffusion method. Ann Clin Lab Sci 3:135–140
The Clinical and Laboratory Standards Institute (2016) Performance Standards for Antimicrobial Susceptibility Testing CLSI supplement M100S
Stepanović S, Vuković D, Hola V et al (2007) Quantification of biofilm in microtiter plates: overview of testing conditions and practical recommendations for assessment of biofilm production by staphylococci. APMIS 115:891–899. https://doi.org/10.1111/j.1600-0463.2007.apm_630.x
Hamed AA, Kabary H, Khedr M, Emam AN (2020) Antibiofilm, antimicrobial and cytotoxic activity of extracellular green-synthesized silver nanoparticles by two marine-derived actinomycete. RSC Adv 10:10361–10367. https://doi.org/10.1039/c9ra11021f
Clokie MRJ, Kropinski AM (2009) Bacteriophages: methods and protocols: isolation, characterization, and interactions, vol 1. Humana Press, New York, pp 971–978
Akhtar M, Viazis S, Diez-Gonzalez F (2014) Isolation, identification and characterization of lytic, wide host range bacteriophages from waste effluents against Salmonella enterica serovars. Food Control 38:67–74. https://doi.org/10.1016/j.foodcont.2013.09.064
Huang C, Shi J, Ma W et al (2018) Isolation, characterization, and application of a novel specific Salmonella bacteriophage in different food matrices. Food Res Int 111:631–641. https://doi.org/10.1016/j.foodres.2018.05.071
Kropinski AM, Mazzocco A, Waddell TE et al (2009) Enumeration of bacteriophages by double agar overlay plaque assay. Methods Mol Biol 501:69–76. https://doi.org/10.1007/978-1-60327-164-6_7
Yamamoto KR, Alberts BM, Benzinger R et al (1970) Rapid bacteriophage sedimentation in the presence of polyethylene glycol and its application to large-scale virus purification. Virology 40:734–744. https://doi.org/10.1016/0042-6822(70)90218-7
Ackermann HW (2012) Bacteriophage electron microscopy. In: Advances in virus research. Elsevier, pp 1–32
Danis-Wlodarczyk K, Olszak T, Arabski M et al (2015) Characterization of the newly isolated lytic bacteriophages KTN6 and KT28 and their efficacy against pseudomonas aeruginosa biofilm. PLoS ONE. https://doi.org/10.1371/journal.pone.0127603
Islam MS, Zhou Y, Liang L et al (2019) Application of a phage cocktail for control of Salmonella in foods and reducing biofilms. Viruses. https://doi.org/10.3390/v11090841
Kostaki M, Chorianopoulos N, Braxou E et al (2012) Differential biofilm formation and chemical disinfection resistance of sessile cells of Listeria monocytogenes strains under monospecies and dual-species (with Salmonella enterica) conditions. Appl Environ Microbiol 78:2586–2595. https://doi.org/10.1128/AEM.07099-11
Chen CY, Chen YH, Lu PL et al (2012) Proteus mirabilis urinary tract infection and bacteremia: risk factors, clinical presentation, and outcomes. J Microbiol Immunol Infect 45:228–236. https://doi.org/10.1016/j.jmii.2011.11.007
Adamus-Bialek W, Zajac E, Parniewski P, Kaca W (2013) Comparison of antibiotic resistance patterns in collections of Escherichia coli and Proteus mirabilis uropathogenic strains. Mol Biol Rep 40:3429–3435. https://doi.org/10.1007/s11033-012-2420-3
Maszewska A, Moryl M, Wu J et al (2021) Amikacin and bacteriophage treatment modulates outer membrane proteins composition in Proteus mirabilis biofilm. Sci Rep 11:1–12. https://doi.org/10.1038/s41598-020-80907-9
Llor C, Bjerrum L (2014) Antimicrobial resistance: risk associated with antibiotic overuse and initiatives to reduce the problem. Ther Adv Drug Saf 5:229–241
Williams PCM, Isaacs D, Berkley JA (2018) Antimicrobial resistance among children in sub-Saharan Africa. Lancet Infect Dis 18:e33–e44
Amann S, Neef K, Kohl S (2019) Antimicrobial resistance (AMR). Eur J Hosp Pharm 26:175–177. https://doi.org/10.1136/ejhpharm-2018-001820
Esmael A, Hassan MG, Amer MM et al (2020) Antimicrobial activity of certain natural-based plant oils against the antibiotic-resistant acne bacteria. Saudi J Biol Sci 27:448–455. https://doi.org/10.1016/j.sjbs.2019.11.006
Awad HA, Mohamed MH, Badran NF et al (2016) Multidrug-resistant organisms in neonatal sepsis in two tertiary neonatal ICUs, Egypt. J Egypt Public Health Assoc 91:31–38. https://doi.org/10.1097/01.EPX.0000482038.76692.3
Sabry NA, Farid SF, Dawoud DM (2014) Antibiotic dispensing in Egyptian community pharmacies: an observational study. Res Soc Adm Pharm. https://doi.org/10.1016/j.sapharm.2013.03.004
Ibrahim OHM (2012) Evaluation of drug and antibiotic utilization in an Egyptian university hospital: an interventional study. Intern Med Open Access 02:1–3. https://doi.org/10.4172/2165-8048.1000109
De J, Sosa A, Byarugaba DK, Amabile-Cuevas CF et al (2010) Antimicrobial resistance in developing countries. Springer
Abdelkader MM, Aboshanab KM, El-Ashry MA, Aboulwafa MM (2017) Prevalence of MDR pathogens of bacterial meningitis in Egypt and new synergistic antibiotic combinations. PLoS ONE 12:e0171349. https://doi.org/10.1371/journal.pone.0171349
Serry FM, Gomaa SE, Abbas HA (2018) Antimicrobial resistance of clinical Proteus mirabilis isolated from different sources. Zagazig J Pharm Sci 27:57–63. https://doi.org/10.21608/zjps.2018.38156
Azeredo J, Sutherland I (2008) The use of phages for the removal of infectious biofilms. Curr Pharm Biotechnol 9:261–266. https://doi.org/10.2174/138920108785161604
Morozova V, Kozlova Y, Shedko E et al (2016) Lytic bacteriophage PM16 specific for Proteus mirabilis: a novel member of the genus Phikmvvirus. Arch Virol 161:2457–2472. https://doi.org/10.1007/s00705-016-2944-2
Yazdi M, Bouzari M, Ghaemi EA (2018) Isolation and characterization of a lytic bacteriophage (vB-PmiS-TH) and its application in combination with ampicillin against planktonic and biofilm forms of Proteus mirabilis isolated from urinary tract infection. J Mol Microbiol Biotechnol 28:37–46. https://doi.org/10.1159/000487137
Thompson RW (2018) The isolation and characterisation of Proteus mirabilis bacteriophages and their effect on the colonisation and blockage of urinary catheters. University of the West of England
Koskella B, Meaden S (2013) Understanding bacteriophage specificity in natural microbial communities. Viruses 5:806–823
Chan BK, Abedon ST, Loc-Carrillo C (2013) Phage cocktails and the future of phage therapy. Future Microbiol 8:769–783
Liu N, Lewis C, Zheng W, Fu ZQ (2020) Phage cocktail therapy: multiple ways to suppress pathogenicity. Trends Plant Sci 25:315–317
Author information
Authors and Affiliations
Corresponding author
Ethics declarations
Conflict of interest
The authors declare that they have no conflict of interest.
Additional information
Handling Editor: T. K. Frey.
Publisher's Note
Springer Nature remains neutral with regard to jurisdictional claims in published maps and institutional affiliations.
Supplementary Information
Below is the link to the electronic supplementary material.
Rights and permissions
About this article
Cite this article
Esmael, A., Abo-Elmaaty, S.A., Khafaga, E.M. et al. Efficacy of three lytic bacteriophages for eradicating biofilms of multidrug-resistant Proteus mirabilis. Arch Virol 166, 3311–3322 (2021). https://doi.org/10.1007/s00705-021-05241-5
Received:
Accepted:
Published:
Issue Date:
DOI: https://doi.org/10.1007/s00705-021-05241-5